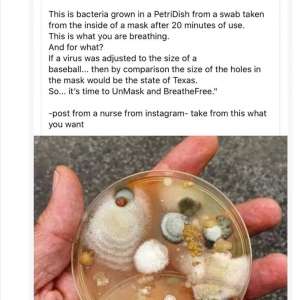
Image

Copacetic Cindy
@CindyCopacetic
30 January, 08:06
Woohoo...Lights on!
We made it through the 10 dark nights...
This guy also showed the Washington Monument was lit up!😎
https://youtu.be/I92K2V_Sh...
We made it through the 10 dark nights...
This guy also showed the Washington Monument was lit up!😎
https://youtu.be/I92K2V_Sh...
Notice: Undefined index: tg1tga_access in /home/admin/www/anonup.com/themes/default/apps/timeline/post.phtml on line 396
Veronica Wolski
@ThePeoplesBridge
30 January, 11:40
I love this site, but I'm one of the few remaining 'snarky accounts' on Twitter for some unkown reason, so I feel a responsibility to help people stay hopeful over there.
#ThePeoplesBridge
#StayTheCourse
#ThePeoplesBridge
#StayTheCourse
Notice: Undefined index: tg1tga_access in /home/admin/www/anonup.com/themes/default/apps/timeline/post.phtml on line 396
30 January, 04:50
#wwg1wga #TheGreatAwakening #nothingcantopwhatiscoming #GodWins
Remember this? Joan Rivers "outing" Big Mike? Joan "dies" 2 weeks later...
From The Great Awakening-telegram
Remember this? Joan Rivers "outing" Big Mike? Joan "dies" 2 weeks later...
From The Great Awakening-telegram
Notice: Undefined index: tg1tga_access in /home/admin/www/anonup.com/themes/default/apps/timeline/post.phtml on line 396
Sabrina Gal
@Sabrinagal
30 January, 02:23
Notice: Undefined index: tg1tga_access in /home/admin/www/anonup.com/themes/default/apps/timeline/post.phtml on line 396
Mac 691
@Mac691
30 January, 11:54
#NOMORECORPORATIONFROMUSA
# wwg1wga#MAGA
#TheGreatAwakening
#elstormisuponus #KAG
@ mrdeeds1111 Raisin_Cain @Sparkledocawake @DianAandDennis @MrsClaus
@martingeddes @ghostezra @intheMatrixxx
# wwg1wga#MAGA
#TheGreatAwakening
#elstormisuponus #KAG
@ mrdeeds1111 Raisin_Cain @Sparkledocawake @DianAandDennis @MrsClaus
@martingeddes @ghostezra @intheMatrixxx
Notice: Undefined index: tg1tga_access in /home/admin/www/anonup.com/themes/default/apps/timeline/post.phtml on line 396
pan axxxa
@panaxxxa
30 January, 11:37
Notice: Undefined index: tg1tga_access in /home/admin/www/anonup.com/themes/default/apps/timeline/post.phtml on line 396
LARRY SMALL II
@NUTHA1BITESDUST
29 January, 03:01
Notice: Undefined index: tg1tga_access in /home/admin/www/anonup.com/themes/default/apps/timeline/post.phtml on line 396
QPatriot17 #WWG1WGA
@QPatriot17
30 January, 03:58
Make this Viral
Patriots Worldwide are United!
FROM SEA TO SHINING SEA!
Follow Telegram: https://t.me/QPatriot0
Follow @QPatriot17
#wwg1wga
#MAGA
#TheGreatAwakening
#thestormisuponus
#Nothingcanstopwhatiscoming
#GodWins
Patriots Worldwide are United!
FROM SEA TO SHINING SEA!
Follow Telegram: https://t.me/QPatriot0
Follow @QPatriot17
#wwg1wga
#MAGA
#TheGreatAwakening
#thestormisuponus
#Nothingcanstopwhatiscoming
#GodWins
Notice: Undefined index: tg1tga_access in /home/admin/www/anonup.com/themes/default/apps/timeline/post.phtml on line 396
Doq Holliday
@doqholliday
30 January, 09:30
DC continues to look more and more like a prison every day. You know [they] aren't doing it because DC is sacred to them. It's their cult holy land. It's been the place where more freedom robbers have gathered than any other place on earth. I'm glad it's looking like prison.
Notice: Undefined index: tg1tga_access in /home/admin/www/anonup.com/themes/default/apps/timeline/post.phtml on line 396
Preacher 2020
@Preacher2020
30 January, 12:01
Notice: Undefined index: tg1tga_access in /home/admin/www/anonup.com/themes/default/apps/timeline/post.phtml on line 396
Only followers of this user (MrDeeds1111) can see their posts
WeAre AllOne
@WeAreAllOne333
29 January, 06:59
Notice: Undefined index: tg1tga_access in /home/admin/www/anonup.com/themes/default/apps/timeline/post.phtml on line 396
NoMercy 2Q21
@NoMercy2Q21
30 January, 08:53
Attorney General Ken Paxton 👍
In general, this situation is a perfect example of how ordinary people can unite and fight against big corporations.
#wwg1wga
#TheGreatAwakening
In general, this situation is a perfect example of how ordinary people can unite and fight against big corporations.
#wwg1wga
#TheGreatAwakening
Notice: Undefined index: tg1tga_access in /home/admin/www/anonup.com/themes/default/apps/timeline/post.phtml on line 396
Veronica Wolski
@ThePeoplesBridge
27 January, 12:49
Notice: Undefined index: tg1tga_access in /home/admin/www/anonup.com/themes/default/apps/timeline/post.phtml on line 396
SAR 1776Q
@SAR1776Q
27 January, 09:05
#TheGreatAwakening is bigger than most understand... ;)
Notice: Undefined index: tg1tga_access in /home/admin/www/anonup.com/themes/default/apps/timeline/post.phtml on line 396
28 January, 12:09
JUST IN - Class action complaint filed in the southern district of New York against RobinhoodApp (via Fox LJMoynihan)
https://twitter.com/disclo...
https://twitter.com/disclo...
Notice: Undefined index: tg1tga_access in /home/admin/www/anonup.com/themes/default/apps/timeline/post.phtml on line 396
P.J. 777
@HiiiPow3r
28 January, 01:56
From Techno Fog: Detective Recarey describes Epstein's "scheme" to use assistants to recruit girls.
Ghislaine Maxwell has already been charged.
Currently, the FBI/DOJ has enough info to charge these assistants as conspirators. #Fooked
Read the unsealed testimony here: https://t.co/vGqXLdsBAg?am...
https://twitter.com/Techno...
Ghislaine Maxwell has already been charged.
Currently, the FBI/DOJ has enough info to charge these assistants as conspirators. #Fooked
Read the unsealed testimony here: https://t.co/vGqXLdsBAg?am...
https://twitter.com/Techno...
Notice: Undefined index: tg1tga_access in /home/admin/www/anonup.com/themes/default/apps/timeline/post.phtml on line 396
Sea Shells
@EyesWideOpen
28 January, 04:40
Notice: Undefined index: tg1tga_access in /home/admin/www/anonup.com/themes/default/apps/timeline/post.phtml on line 396
28 January, 01:30
Notice: Undefined index: tg1tga_access in /home/admin/www/anonup.com/themes/default/apps/timeline/post.phtml on line 396
Kitkat Reborn
@KitkatReborn
28 January, 05:23
In response PatriotsFight Dshep WWG1WGA to her Publication
Notice: Undefined index: tg1tga_access in /home/admin/www/anonup.com/themes/default/apps/timeline/post.phtml on line 396
28 January, 06:05
Clear cookies before setting up a new Twitter account. DO NOT use the app.
Notice: Undefined index: tg1tga_access in /home/admin/www/anonup.com/themes/default/apps/timeline/post.phtml on line 396
Qanon Plus
@BandOfBrothersQ
28 January, 04:12
🚨🚨🚨If you need to see any of Donald Trump's past tweets, go to🚨🚨🚨 https://www.thetrumparchiv...
🇺🇲🇺🇲 Follow our Telegram channel at qanonplus
and chatroom at @BandOfBrothersQ
also patriotbusiness
and share 🇺🇲🇺🇲
🇺🇲🇺🇲 Follow our Telegram channel at qanonplus
and chatroom at @BandOfBrothersQ
also patriotbusiness
and share 🇺🇲🇺🇲
Trump Twitter Archive
All 50,000+ of Trump's tweets, instantly searchable
https://www.thetrumparchive.com/Notice: Undefined index: tg1tga_access in /home/admin/www/anonup.com/themes/default/apps/timeline/post.phtml on line 396
Leen Zap
@Leenzap
28 January, 10:04
In response Patriot Girl17 to her Publication
#FakeFauci is one of the most deplorable humans to ever walk the face of thos earth!! Read. Read. Read. It's all out there. Not only the HcQ coverup. Look into the Aids epidemic and Bactrim. Look how much $$$ he & his NIH get every year from our own gov't. And finally, realize that he is ultimately responsible for the "gain of function" research on contagious viruses and the how/why of the Chyna virus even being at that particular Chinese lab!
The man is despicable and is responsible for EVERY death from COVID19 and should be held responsible for the crime of humanity!!!
The man is despicable and is responsible for EVERY death from COVID19 and should be held responsible for the crime of humanity!!!
Notice: Undefined index: tg1tga_access in /home/admin/www/anonup.com/themes/default/apps/timeline/post.phtml on line 396
Sunny Flowers
@SunnyFlowers17
29 January, 09:46
In response Cowboy w2b to his Publication
Notice: Undefined index: tg1tga_access in /home/admin/www/anonup.com/themes/default/apps/timeline/post.phtml on line 396
Red P 2K71
@Reys_baby
27 January, 01:43
In response Vincent Kennedy⍟ to his Publication
Notice: Undefined index: tg1tga_access in /home/admin/www/anonup.com/themes/default/apps/timeline/post.phtml on line 396
dan7gtar Q-Tip
@dan7gtar
29 January, 02:46
Notice: Undefined index: tg1tga_access in /home/admin/www/anonup.com/themes/default/apps/timeline/post.phtml on line 396
Ghost Ezra
@GhostEzra
29 January, 01:56
Just got the 3rd EAS alert in the last 12 hours. We are moving into the shit's happening soon category.
Notice: Undefined index: tg1tga_access in /home/admin/www/anonup.com/themes/default/apps/timeline/post.phtml on line 396
Cob Cob
@Colob123
29 January, 02:45
Notice: Undefined index: tg1tga_access in /home/admin/www/anonup.com/themes/default/apps/timeline/post.phtml on line 396
Warren Arcand
@Earlofsandwiches
28 January, 09:25
In response Carol Roberts to her Publication
Notice: Undefined index: tg1tga_access in /home/admin/www/anonup.com/themes/default/apps/timeline/post.phtml on line 396
Patriot Girl17
@Patriotgirl17
28 January, 07:42
Notice: Undefined index: tg1tga_access in /home/admin/www/anonup.com/themes/default/apps/timeline/post.phtml on line 396